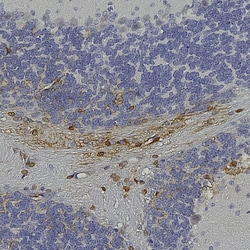

Promotional price valid on web orders only. Your contract pricing may differ. Interested in signing up for a dedicated account number?
Learn More
Learn More
Invitrogen™ GFP Polyclonal Antibody
Chicken Polyclonal Antibody
Supplier: Invitrogen™ PA5143569
Description
GFP Polyclonal Antibody for Western Blot, ICC/IF, IHC (P)
The jellyfish Aequorea victoria contains green fluorescent protein (GFP Tag) that emits light in the bioluminescence reaction of the animal. GFP has been used widely as a reporter protein for gene expression in eukaryotic and prokaryotic organisms, and as a protein tag in cell culture and in multicellular organisms. As a fusion tag, GFP can be used to localize proteins, to study their movement or to research the dynamics of the subcellular compartments where these proteins are targeted. GFP technology has revealed considerable new insights in the physiological activities of living cells. GFP is a 27 kDa monomeric protein, which autocatalytically forms a fluorescent pigment. The wild type protein absorbs blue light (maximally at 395nm) and emits green light (peak emission 508nm) in the absence of additional proteins, substrates, or co-factors. GFP fluorescence is stable, species independent and is suitable for a variety of applications. GFP has been used extensively as a fluorescent tag to monitor gene expressin and protein localization. Moreover, other applications for GFP include its use in assessing protein protein interactions in the yeast two hybrid system, and in measuring distances between proteins in fluorescence energy transfer (FRET) experiments.
Specifications
| GFP | |
| Polyclonal | |
| Unconjugated | |
| GFP; GFP tag; GFP2; green fluorescence; green fluorescent; Turbo eGFP | |
| Recombinant protein purified from E. coli. | |
| 100 μL | |
| Primary | |
| Store at 4°C short term. For long term storage, store at -20°C, avoiding freeze/thaw cycles. | |
| Liquid | |
| Chemical |
| Immunohistochemistry (Paraffin), Western Blot, Immunocytochemistry | |
| 1 mg/mL | |
| PBS with 50% glycerol and 5mM sodium azide | |
| Chicken | |
| Affinity chromatography | |
| RUO | |
| Tag | |
| Antibody | |
| IgY |
Product Content Correction
Your input is important to us. Please complete this form to provide feedback related to the content on this product.
Product Title
Spot an opportunity for improvement?Share a Content Correction